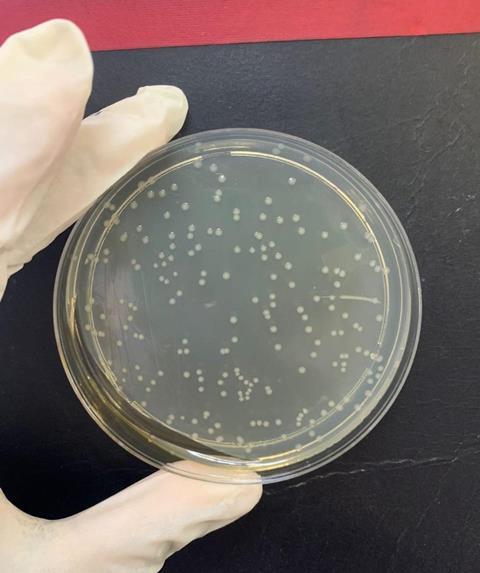
Dj Ajose 5

We caught up with Daniel Jesuwenu Ajose, a Postdoctoral Research Fellow at the School of Biology and Environmental Sciences, University of Mpumalanga in South Africa, who is one of the newest Junior Editors with Letters in Applied Microbiology.

What drew you to become a Junior Editor for LAM and what excites you about the role?
I was drawn to the Junior Editor role for LAM because of my strong background in applied microbiology, particularly my research on antimicrobial resistance (AMR), plant-derived bioactive compounds, and green nanotechnology. Through my doctoral and postdoctoral work, I have been actively involved in generating and publishing scientific findings in peer-reviewed journals, as well as reviewing manuscripts for several international journals. These experiences have given me a deep appreciation for the importance of rigorous peer review, clarity in scientific communication, and maintaining high publication standards. These values closely align with LAM’s mission.
In addition, my involvement in coordinating academic writing retreats and facilitating research writing workshops has strengthened my ability to critically engage with scientific manuscripts and support others in improving their work. This has further motivated my interest in contributing to the editorial process, where I can help shape and refine high-quality research outputs.
What excites me most about this role is the opportunity to engage with cutting-edge research across diverse areas of applied microbiology, including AMR, biocontrol strategies, and sustainable biotechnology. I am particularly enthusiastic about contributing to a journal that publishes work with real-world impact while also developing my editorial skills, critical evaluation abilities, and understanding of the academic publishing landscape.
This role aligns naturally with my research, teaching, and reviewing experience and presents an opportunity to contribute meaningfully to advancing the quality and impact of scientific research in applied microbiology.
What first sparked your interest in microbiology and how did your career develop?
My interest in microbiology began during my undergraduate studies, but it was rooted in an earlier aspiration to pursue a career in medicine. Although I was unable to secure a place to study medicine, my strong interest in health-related matters led me to microbiology, where I discovered an equally powerful way to understand and address human disease. This shift in direction ultimately became defining, as I was introduced to the unseen microbial world and its profound impact on human health and the environment.
I remember being particularly struck by how microorganisms (though invisible) could determine disease spread, food safety, and the balance of entire ecosystems. That realization sparked a curiosity that stayed with me and ultimately shaped my academic path.

I chose to pursue this interest further during my MSc, where I worked on pathogens associated with upper respiratory tract infections and investigated the antimicrobial potential of plant extracts. This experience was a turning point for me, as it introduced me to the idea that nature itself could provide solutions to microbial challenges. It deepened my interest in exploring alternative approaches to combating infections, especially amid the growing threat of antibiotic resistance.
My doctoral research at North-West University marked a significant moment in my career. I worked on multidrug-resistant (MDR) pathogens using molecular and genomic tools while also exploring green nanotechnology and plant-derived nanoparticles as potential biocontrol agents. This phase allowed me to connect different areas of microbiology: infectious diseases, biotechnology, and sustainable solutions and solidified my research direction.

Since completing my PhD, my career has grown to include postdoctoral research, teaching, and mentorship. I have had the opportunity to supervise students, publish research, and facilitate academic writing initiatives, all of which have strengthened my ability to communicate science effectively. At the same time, my experience as a journal reviewer has given me a deeper appreciation for the rigor and responsibility involved in scientific publishing.
Looking back, what started as curiosity about the invisible world has developed into a career focused on addressing real-world challenges, particularly AMR, through research, collaboration, and scientific communication.
What’s the microbe that most fascinates you and why?
One group of microbes that continues to fascinate me is Escherichia coli O157:H7, particularly because of my research experience working with MDR strains. Early in my research, I encountered how a single bacterial species commonly found in food and the environment can evolve into a highly virulent, resistant pathogen with serious public health implications. That duality, of being both a normal inhabitant and a dangerous pathogen, is something I find incredibly compelling.
What draws my interest even more is its adaptability. Through my work in molecular characterization and whole-genome analysis, I have seen how this organism acquires resistance genes, forms biofilms, and persists in challenging environments, such as food systems and agricultural settings. It highlights not only the complexity of microbial evolution but also the urgency of addressing AMR.
At the same time, studying organisms like this has pushed me to think beyond conventional antibiotics and explore alternative strategies, including plant-derived compounds and nanoparticle-based interventions. In that sense, this microbe has not only fascinated me scientifically but has also shaped the direction of my research and my interest in developing sustainable solutions to microbial threats.
What real-world problem would you eventually love to solve with microbiology?
A real-world problem I would ultimately love to solve is the growing crisis of AMR, particularly its impact on food systems, public health, and sustainable agriculture. Through my research, I have seen how MDR pathogens continue to emerge in environments such as livestock, food products, and water systems, making infections increasingly difficult to treat and control.
What motivates me is not only the scale of the problem, but also the opportunity to approach it differently. I am especially interested in developing alternative antimicrobial strategies derived from natural sources, including plant-associated microbes and bioactive compounds, as well as green nanotechnology-based solutions. The goal is to reduce reliance on traditional antibiotics and to foster more sustainable, effective methods for real-world application.

In the long term, I would like my work to contribute to practical interventions, whether through novel antimicrobial compounds, biocontrol agents, or integrated approaches that can reduce the burden of resistant infections while supporting food safety and environmental health. For me, microbiology offers a powerful lens not only to understand this problem but also to be part of the solution.
How important do you think the role of applied microbiology could be in solving some of the world’s problems?
Applied microbiology, in my view, is central to addressing many of the world’s most pressing challenges because it translates fundamental microbial knowledge into practical, real-world solutions. From my experience, it is not just important; it is indispensable.
One of the clearest examples is the fight against AMR, where applied microbiology is driving the development of alternative therapeutics, biocontrol strategies, and improved diagnostic tools. Beyond human health, it plays a critical role in food safety and security, helping to monitor and control pathogens in food systems while also improving agricultural productivity through microbial-based inputs.
Applied microbiology is also key to advancing sustainable agriculture, particularly through the use of beneficial microbes to improve soil health, enhance nutrient cycling, and promote plant growth. In the context of environmental challenges, it contributes to bioremediation, waste management, and the development of eco-friendly technologies that reduce reliance on harmful chemicals.

What makes applied microbiology especially powerful is its versatility. It operates at the intersection of health, agriculture, and the environment. In my own work, I have seen how integrating microbiology with approaches such as natural product research and green nanotechnology can open new pathways to tackle complex problems more sustainably.
Ultimately, I believe applied microbiology will continue to be a cornerstone in solving global challenges, particularly as we move toward more integrated, “One Health” approaches that recognise the interconnectedness of human, animal, and environmental health.
What opportunities will this role bring for you?
This role represents an important step in my development within academic publishing. While I have experience as a reviewer and active researcher, serving as a Junior Editor will allow me to engage more deeply with the editorial process and understand how editorial decisions shape the quality and impact of research in applied microbiology.
I am particularly excited about the opportunity to engage with diverse and emerging research areas, which will strengthen my critical evaluation skills and broaden my perspective beyond my immediate research focus. Contributing to work addressing challenges such as AMR and sustainable agriculture is especially motivating.
This position also aligns with my long-term goal of contributing to scientific leadership and knowledge dissemination. It serves as a foundation for growth in editorial roles, supports authors, and maintains high standards in scientific publishing.
Is there anything else you would like to add?
I would like to add that I am particularly interested in gaining deeper insight into the decision-making processes that underpin manuscript handling and publication. Understanding how editorial priorities, reviewer input, and journal standards are balanced to ensure timely and fair outcomes is especially valuable to me.
I am also keen to contribute to improving efficiency within the editorial workflow, particularly in maintaining consistency and timeliness throughout the review process. This role offers me the opportunity to engage with these aspects of publishing in a meaningful and practical way.
Letters in Applied Microbiology is an inclusive and accessible journal that supports and develops the next generation of applied microbiologists. Find out about submitting your research HERE.
Topics
- Antimicrobial Resistance
- Applied Microbiology International
- Be inspired
- biocontrol
- Community
- Daniel Jesuwenu Ajose
- Escherichia coli O157:H7
- Infection Prevention & Control
- Infectious Disease
- Middle East & Africa
- nanotechnology
- North-West University
- One Health
- Pharmaceutical Microbiology
- plant-derived bioactive compounds
- Publishing
- University of Mpumalanga
No comments yet